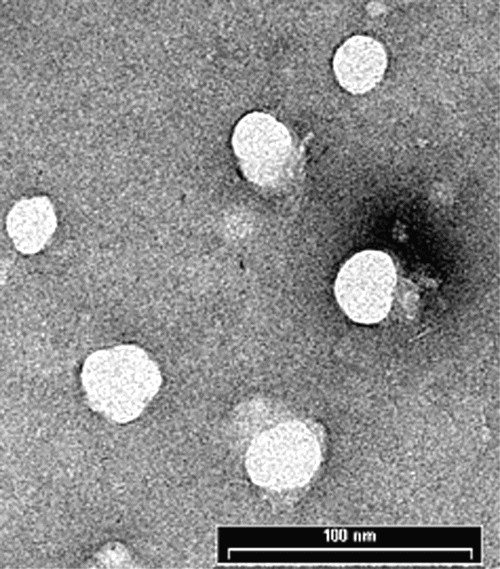

J Pharm Pharmaceut Sci (www.ualberta.ca/~csps) 7(1):38-46, 2004
In vitro cytotoxicity studies of hydrogel pullulan nanoparticles prepared by aot/n-hexane micellar system.
Mona Gupta1
Division of Biochemistry and Molecular Biology, IBLS, Davidson Building, University of Glasgow, Glasgow, Scotland, United KingdomAjay Kumar Gupta
Centre for Cell Engineering, IBLS, Joseph Black Building, University of Glasgow, Glasgow, Scotland, United KingdomReceived 16 June 2003, Revised 27 November 2003, Accepted 10 February 2004, Published 13 February 2004
PDF Version
Abstract
PURPOSE: The purpose of this study was to prepare crosslinked pullulan nanoparticles encapsulating bioactive molecules inside the aqueous core of Aerosol-OT/n-hexane reverse micellar droplets with narrow size distribution for drug and gene delivery applications. METHODS: The nanoparticles have been characterised by various physico-chemical methods such as dynamic light scattering (DLS), transmission electron microscopy (TEM), scanning electron microscopy (SEM), loading capacity and in vitro release behaviour in aqueous buffer. The influence of these nanoparticles on human dermal fibroblasts in vitro has been assessed in terms of cell adhesion, cytotoxicity and light microscopy. RESULTS: Size distribution studies using DLS and TEM show that the particles are spherical in shape with size of 42.0±2.5 nm diameter. Release of FITC-Dex from nanoparticles increased with time with 75% of dye released in 6 hours, while only 40% of the dye was released in the initial 2 hours. Results from cell adhesion/viability assay suggest that the pullulan nanoparticles are non-toxic to cells and do not cause any distinct harm to cells. Fibroblasts were healthy and maintained their morphology and adhesion capacity. CONCLUSIONS: These studies indicated that these nanoparticles have further merit as possible carriers for genes and nucleotide drugs for intracellular delivery.
iNTRODUCTION
The extensive development of synthetic peptides, proteins, genes and nucleotides for therapy has resulted in greater use of nanoparticles to target these bioactive macromolecules to specific cell type while protecting these macromolecules from enzymatic degradation (1). In addition, nanoparticles have been proposed for the treatment of many diseases that need constant drug concentration in the blood or drug targeting to specific cells or organs (2). In this respect, nanoencapsulated therapeutic agents such as antineoplastic drugs have been used with the aim to selectively target antitumor agents and to obtain higher drug concentration at the tumour site (3). This achievement appears to be important since many antineoplastic agents have several adverse side effects. Nanoparticles can be utilised to treat diseases that require a sustained presentation of the drug at several anatomical sites. In this regard, the direct relationship between route of administration and particle size should be considered (4).
Typically, following systemic administration, small particles with diameters of less than 5-10 nm are rapidly removed through from tissues via extravasation, while larger particles with diameters ranging from 10 to 70 nm are small enough to penetrate even very small capillaries throughout the body, and therefore offer the most effective distribution in certain tissues (5-6). Slightly larger particles, ranging from 70 to 200 nm, demonstrate the most prolonged circulation times (5, 7). In contrast, larger particles with diameters greater than 200 nm are usually sequestered by the spleen because of mechanical filtration and are eventually removed by phagocytes (5, 8). This results in decreased blood circulation times.
Nanoparticles may be comprised of several materials including both synthetic and natural polymers. They can be classified as non-degradable and biodegradable. Polymers based on poly (ethylene-co-vinyl acetate) are typical example of non-degradable system for protein and nucleotide delivery (9-10). Biodegradable systems have an advantage over non-degradable systems in that they avoid matrix retrieval that results in improved patient compliance and lower therapeutic cost. Biodegradable systems include use of poly (lactic-co-glycolic acid) (11-13). These systems can be further classified into hydrophobic polymer systems such as poly (lactic-co-glycolic acid) nanoparticles (14-15) or hydrophilic polymer systems such as gelatin, polyethylene glycol (PEG) or pullulan (16-18). Hydrophobic polymeric systems are not compatible with water-soluble proteins or nucleotide drugs and the hydrophobicity of polymers may induce unfolding of protein and nucleotide drugs resulting in loss of biological activity.
Pullulan is a water soluble, neutral linear polysaccharide consisting of a-1, 4 and a-1, 6 glycosidic linkages (19). Pullulan cannot self-associate in aqueous solution due to its water solubility. Therefore, mostly hydrophobized pullulan have been used as drug delivery carriers (20-22). These hydrophobized pullulan molecules can form relatively monodisperse and colloidally stable nanoparticles (20-30 nm) upon self-aggregation in water. As these hydrogel, nanoparticles have an inner hydrophobic core, only hydrophobic substances including water insoluble drugs or proteins can be complexed or encapsulated into these nanoparticles (20-22).
The aim of this study was to prepare hydrogel nanoparticles of pullulan that can encapsulate water-soluble materials for intracellular delivery and targeting. In this study, pullulan nanoparticles in the narrow size range have been prepared inside the aqueous core of the reverse micelles formed by dissolving dioctylsulfosuccinate sodium salt (Aerosol-OT, AOT) in n-hexane (w/o microemulsion). These nanoparticles can be used to solubilize water-soluble proteins and nucleotide drugs. A water-soluble fluorescent marker molecule, fluoroscein isothiocyanate dextran (FITC-Dex, Mw=19.3 kDa) has been encapsulated in these nanoparticles and the particles are characterized by various physicochemical means such as size measurements, loading capacity and in vitro release behaviour in buffer. The influence of these nanoparticles on human dermal fibroblasts in vitro has been assessed in terms of cell adhesion, cytotoxicity and light microscopy.
Materials and Methods
Materials: All the chemicals were of reagent grade and were used without further purification. Pullulan, (3-(4,5-dimethylthiazol-2-yl)-2,5-diphenyl-tetrazolium bromide) MTT, AOT, n-hexane, FITC-Dex (Mw=19.3 kDa), sodium dihydrogen phosphate, disodium hydrogen phosphate, methanol and acetone were obtained from Sigma-Aldrich chemical company, Dorset, England, U.K. Double distilled water was used for all the experiments.
Preparation of Pullulan Nanoparticles: Pullulan nanoparticles were prepared inside the inner aqueous core of reverse micellar droplets formed by dissolving surfactant, AOT in n-hexane (23). AOT has an advantage over other surfactants in that it can form aggregates in non-polar solvents without the addition of any co-surfactant (24). Two types of crosslinked pullulan nanoparticles i.e. nanoparticles without any FITC-Dex into them (void nanoparticles) and nanoparticles with FITC-Dex (dye-loaded nanoparticles) were prepared. Crosslinking of the nanoparticles was done not only to impart the greater stability to the nanoparticles and drugs inside the nanoparticles but also to control the release kinetics of encapsulated macromolecules. To 50.0 ml of 0.05 M AOT in n-hexane solution, 800 ml of 0.1% w/v aqueous solution of pullulan was added. 10 μl (1.0% v/v) of glutaraldehyde was added to cross-link the nanoparticles. For preparation of FITC-Dex loaded pullulan nanoparticles, 20 ml of FITC-Dex solution (35.0 mg/1 ml in water) was added to above solution. For void pullulan nanoparticles, 20 ml of water (instead of FITC-Dex solution) was added to this solution in order to keep the parameter, Wo, constant (Wo= [water]/ [surfactant]). Both solutions were vortexed for two minutes and stirred overnight at room temperature. The solutions were homogeneous and optically transparent at this stage. Nanoparticles were then recovered from reverse micelles. Briefly, the organic solvent, n-hexane was evaporated off in a rotary evaporator and the particles from remaining dry mass were recovered by precipitation in an excess of acetone-methanol mixture (9:1 ratio). The precipitate was washed 3-4 times with acetone-methanol mixture to remove excess of AOT, the surfactant. Then, particles were resuspended in water followed by dialysis using 12 kD cut off dialysis membrane against double distilled water. Dialysis was done for 3 hours at 4°C with water changed every 30 minutes. The aqueous suspension of the nanoparticles was lyophilised immediately to dry powder before characterisation. Lyophilized powder was easily redispersable in aqueous buffer.
Calculation of Entrapment Efficiency (E %): Entrapment efficiency of the FITC-Dex in nanoparticles was calculated as follows: After separation of nanoparticles from the aqueous buffer, the extract including the repeated washing was collected. To a 100 ml of this solution, 500 ml of phosphate buffer saline (PBS), pH-7.4 was added and the concentration of the FITC-Dex was measured spectrophotometrically at 493 nm using a Shimadzu UV-160A UV-visible recording spectrophotometer. Amount of FITC-Dex present was calculated from the standard curve of the drug. Total amount of FITC-Dex left in the aqueous extract was subtracted from the amount of FITC-Dex originally added in the reaction medium and the entrapment efficiency (E %) was calculated from the ratio of the amount of FITC-Dex entrapped to the total amount of FITC-Dex added x 100.
Dynamic Light Scattering (DLS) Studies: Dynamic light scattering measurements were carried out by using the DLS spectrometer of Zetasizer 3000 from Malvern Instrument (Worcstershire, UK), with a 10 mW He-Ne laser beam at a wavelength of 488 nm at 20°C. A scattering angle of 90° was used. Before DLS analysis, the freeze-dried powder of FITC-Dex loaded particles was dispersed in aqueous buffer and diluted solutions were filtrated through 0.2-micron pore size filtration unit (Millipore, Billerica, MA, U.S.A.). The sample concentration was kept at 1.0 mg/ml. Autocorrelation function of the intensity was analyzed by the method of cumulants analysis to obtain the average diffusion coefficient, D, of the particles and the polydispersity. The hydrodynamic diameter, Dh, was calculated by means of the Stokes-Einstein equation (Dh = kB T / 3 ph D, where kBT is the thermal energy and h is the viscosity of the continuous phase).
Transmission Electron Microscopy (TEM) Studies: Average particle size, size distribution and morphology were examined by Zeiss 902 transmission electron microscope at a voltage of 80kV. The aqueous dispersion of the particles was drop-cast onto a carbon coated copper grid and grid was air dried at room temperature before loading into the microscope.
Scanning electron microscopy (SEM) studies. The aqueous dispersion of the particles was put on a glass coverslip and air dried at room temperature. Once dry, the samples were sputter coated with gold before examination with a Hitachi S800 field emission SEM at an accelerating voltage of 10 keV.
Release Profile of FITC-Dex from Nanoparticles: A known amount of lyophilized powder of crosslinked pullulan nanoparticles loaded with FITC-Dex was dispersed in 10ml of phosphate buffer saline (PBS, pH=7.4). 200ml of the solution was distributed in 27 eppendorf tubes and kept at 37°C. At a predetermined interval of time, the solution was filtered through a UFP2THK24 Millipore filter (100 kD cut off). Free FITC-Dex present in aqueous buffer passed through the filter and its concentration was determined spectrophotometrically at l max= 493 nm.
Cell culture: InfinityTM telomerase-immortalized primary human fibroblasts (hTERT-BJ1, Clonetech Laboratories, Inc., Hampshire, England, U.K.) were seeded onto 13-mm coverslips in a 24 well plate at a density of 1x104 cells per well for 24 hours after which the growth medium was removed and replaced with the medium containing void nanoparticles. For control experiments, medium with no particles was used. The medium used was 71% Dulbecco's modified Eagle's medium (DMEM) (Sigma, Dorset, England, U.K.), 17.5% Medium 199 (Sigma, Dorset, England, U.K.), 9% foetal calf serum (FCS) (Life Technologies Ltd., Paisley, Scotland, U.K.), 1.6% 200 mM L-glutamine (Life Technologies Ltd., Paisley, Scotland, U.K.), and 0.9% 100 mM sodium pyruvate (Life Technologies Ltd., Paisley, Scotland, U.K.). The cells were incubated at 37°C with a 5% CO2 atmosphere.
Cell adhesion assay: The effect of nanoparticles on cell adhesion was determined with cell suspension incubated with or without void nanoparticles. Fibroblasts (h-TERT BJ1) were expanded in monolayer tissue culture. The cells were detached using trypsin-EDTA solution and divided into two individual populations. 1x104 cells/1 ml/1 well were seeded with or without nanoparticles at a concentration of 0.5 mg/ml for 24 hours onto coverslips (13mm diameter; in triplicate) at 37°C in 5% CO2 . The cells were washed twice with PBS, fixed in 4% formaldehyde/PBS (15 minutes, 37°C), washed with PBS again and finally stained for 2 minutes in Coomassie blue in acetic acid/methanol mixture at room temperature. The triplicate cell populations of adhered cells were counted in three separate light fields under a phase contrast microscope using an eyepiece with average normalized to control cell population. The stained samples were observed by light microscopy and digital images of the fibroblasts were captured using a Hamamatsu Argus 20 for image processing.
In vitro cell viability/cytotoxicity studies: The MTT (3-(4,5-dimethylthiazol-2-yl)-2,5-diphenyltetrazolium bromide) assay is a simple non-radioactive colorimetric assay to measure cell cytotoxicity, proliferation or viability. MTT is a yellow, water-soluble, tetrazolium salt. Metabolically active cells are able to convert this dye into a water-insoluble dark blue formazan by reductive cleavage of the tetrazolium ring (25). Formazan crystals, then, can be dissolved and quantified by measuring the absorbance of the solution at 550 nm, and the resultant value is related to the number of living cells. The cytotoxicity of the nanoparticles was determined after 24 and 48 hours incubation with fibroblasts. To determine cell cytotoxicity/viability, the cells were plated at a density of 1x 104 cells/well in 96 well plate at 37°C in 5% CO2 atmosphere. After 24 and 48 hours of culture, the medium in the wells was replaced with the fresh medium containing nanoparticles of varying concentrations. After 24 hours (or 48 hours), 20μl of MTT dye solution (5mg/ml in phosphate buffer pH-7.4) was added to each well. After 4 hours of incubation at 37°C and 5% CO2 for exponentially growing cells and 15 min for steady-state confluent cells, the medium was removed and formazan crystals were solubilized with 200 ml of DMSO and the solution was vigorously mixed to dissolve the reacted dye. The absorbance of each well was read on a microplate reader (DYNATECH MR7000 instruments) at 550 nm. The spectrophotometer was calibrated to zero absorbance using culture medium without cells. The relative cell viability (%) related to control wells containing cell culture medium without nanoparticles was calculated by [A]test / [A] control x 100. Where [A]test is the absorbance of the test sample and [A]control is the absorbance of control sample.
Statistical analysis: All the experiments were repeated three times in triplicate. The statistical analysis of experimental data utilised the Student's t-test and the results were presented as mean ±S.D. Statistical significance was accepted at a level of p<0.05.
Results and Discussion
Crosslinked pullulan nanoparticles were prepared using the highly monodispersed aqueous core of AOT/n-hexane reverse micellar droplets. The surfactant (for example, AOT) when dissolved in non-polar solvents like hexane forms reverse micelles where the polar groups of the surfactant molecules are oriented towards the hydrophilic interior enclosing an aqueous core, and the hydrophobic chains are extended outwards in the non-polar phase (26). Since these cores are hydrophilic, the aqueous solution of pullulan and cross-linking agent were dissolved in this aqueous core of the reverse micelles. Cross-linking of pullulan and subsequent formation of nanoparticles take place inside these cores.
The size of the nanoparticles as measured by DLS was found to be 42.0±2.5 nm diameter (Figure-1).
Figure 1: Typical size distribution of FITC-Dex entrapping pullulan nanoparticles by DLS measurements prepared via AOT/n-hexane reverse micelles. The particles are highly monodispersed with particle size of 42.0±2.5 nm diameter.
The particles were highly monodispersed with narrow size distribution. Several TEM images of the particles were taken at magnification of 140,000 (Figure-2).
Figure 2: Transmission electron microscope picture of pullulan nanoparticles taken at a voltage of 80kV. The aqueous dispersion of the particles was drop-cast onto a carbon coated copper grid and grid was air dried at room temperature before loading into the microscope.
Average size of the particles was determined by measuring the size of around 200 particles. From TEM, average particle size was found to be 44.0 nm with a polydispersity index of 2.76 nm, which is in agreement with the size obtained from DLS measurements. The TEM picture showed that the particles were spherical in shape.
The size of the inner aqueous core of reverse micelles is in nanometer range (27) so the pullulan nanoparticles prepared inside these nanoreactors were found to be very small in size (less than 50 nm) with narrow size range distribution. Another advantage of utilising this type of reverse micellar system for nanoparticle formation is that the size of nanoparticles can be controlled by modulating the size of aqueous micellar core (27). The entrapment efficiency of the nanoparticles for the drug FITC-Dex was found to be approximately 90%.
In order to study the stability of FITC-Dex loaded pullulan nanoparticles (crosslinked with glutaraldehyde) from the aqueous dispersion system, the release of drug from nanoparticles was measured in the phosphate buffered saline (PBS). Results from figure-3 showed that the release of drug from nanoparticles increased with time with 75% of FITC-Dex released in 6 hours, while only 40% of the drug was released in initial 2 hours.
Figure 3: Release profile of FITC-Dex from crosslinked pullulan nanoparticles in PBS (pH-7.4) at 37°C. Free FITC-Dex released from the nanoparticles was filtered through a Millipore filter and its concentration was determined spectrophotometrically.
This is probably due to time dependent swelling of densely cross-linked pullulan matrix in aqueous solution and subsequent release of the macromolecular drug (20). The swelling of matrix was also seen from the SEM images (figure-4) of the nanoparticles in dried form and after swelling in buffer (PBS, pH-7.4) for four hours.
Figure 4: Scanning electron microscope pictures of pullulan nanoparticles. The particles were sputter coated with gold before examination. The picture shows (a) drug loaded pullulan nanoparticle in dry state and (b) Highly swelled pullulan nanoparticle in aqueous buffer after releasing the drug at 37°C.
In recent years, the strategy of utilising nanoparticles as a carrier system for cell specific targeting and delivery of drugs has gained an increased interest. The immediate goal of designing any delivery vehicle would be to provide a system that promotes maximal cell adhesion with minimal inflammatory cell response. The effect of nanoparticles on the adhesion of cells onto the glass surface was determined by counting the number of cells adhered to glass surface. Figure-5 shows that the particles had no distinct effect on the adhesion capacity of the cells with 90% of cells adhered to glass coverslips as compared to control cells (without particles).
Figure 5: Graphical representation of number of cells adhered onto glass coverslips. 10,000 cells were seeded with or without nanoparticles at concentration of 0.5 mg/ml for 24 hours onto 13 mm coverslips at 37°C (n=3, counted in triplicate in individual microscope fields, experiment repeated three times in triplicate).
The general morphology of the fibroblasts incubated with nanoparticles after staining with Coommassie blue is shown in figure-6. The figure shows that the cells were well spread and there was no distinct change in morphology after 24-hour incubation with pullulan nanoparticles relative to control cells.
Figure 6: Coomassie blue stained cells (a) control and (b) incubated with pullulan nanoparticles; (n=3). The figure shows that the cells are well spread and there is no distinct change in morphology after 24-hour incubation with pullulan nanoparticles relative to control cells.
The proliferation/viability of fibroblasts was measured by MTT assay after culturing for 24 and 48 hours. As it is evident from figure-7, the cytotoxicity of the nanoparticles increases in relation to increasing pullulan concentration.
Figure 7: Cytotoxicity profile of pullulan nanoparticles on human fibroblasts after 24 and 48 hours incubation as measured by MTT assay (experiment repeated three times in triplicate). Percent viability of fibroblasts is expressed relative to control cells (n=6). 1x 104 cells/well in 96 well plate at 37°C atmosphere were cultured for 24 hours and the medium in the wells was replaced with the fresh medium containing nanoparticles of varying concentrations.
After 24 hours, the fibroblasts were found to be more than 100% viable relative to control cells at nanoparticles concentrations as high as 1mg/ml. However, after 48 hours incubation with nanoparticles, the percentage viability of the fibroblasts decreased slightly but the difference was not statistically different from the results obtained after 24 hours. Toxicity of these nanoparticles was sufficiently low on human fibroblasts since no significant decrease in cell viability was observed in cells interacting with pullulan nanoparticles for prolonged periods.
It was observed from cell adhesion experiments that pullulan nanoparticles did not affect the adhesion of cells as compared to control. Moreover, the MTT assay also supported these results. Taken together, the results from the MTT assay and cell adhesion suggest that the pullulan nanoparticles are non-toxic to cells and do not cause any apparent harm to cells. The cells were healthy and maintained their morphology and adhesion capacity. It is known that cell adhesion is mediated by the interaction of surface proteins such as integrins with proteins in the extracellular matrix or on the surface of other cells or particles (28-29). The phenomenon of cell adhesion is of crucial importance in governing a range of cellular functions including cell growth, migration, differentiation, survival, and tissue organisation (30). Thus, the carrier system should not elicit a generic and chronic inflammatory response that can ultimately result in failure to achieve normal cell growth and function at the cell-particle surface.
Pullulan is a water-soluble, viscous polysaccharide consisting of three a-1, 4-linked glucose molecules that are repeatedly polymerized by a-1, 6-linkages on the terminal glucose. Pullulan has been used extensively as an additive in the food industry. The principal advantages of pullulan, a nonionic polysaccharide, as a macromolecular drug carrier are high water solubility, no toxicity, lack of immunogenicity and usefulness as a plasma expander (31-33). In addition, Kaneo et al (34) have shown the evidence for receptor-mediated hepatic uptake of pullulan in rats. Their results have indicated that the pullulan has high affinity for asialoglycoprotein receptors on hepatocytes. Subsequently, the pullulan - asialoglycoprotein receptors complex is internalized into the hepatocyte via receptor-mediated endocytosis. Xi et al (35) studied the targeting of interferon to the liver through chemical conjugation with pullulan. Therefore, hydrophilic, nanometer sized pullulan particles, which have the ability to encapsulate the water-soluble drugs, proteins and nucleotides, can be proposed as new controlled release drug delivery and targeting systems.
Conclusions
Pullulan nanoparticles were synthesized using the aqueous core of the reverse micelles formed by dissolving a surfactant AOT in n-Hexane. Since these nanoparticles were prepared in the aqueous core of the reverse micelles, the size of these nanoparticles was found to be less than 50 nm with narrow size distribution. The size of these nanoparticles can be controlled by modulating size of the aqueous core of reverse micellar droplets. The release of FITC-Dex from the pullulan nanoparticles was found to increase with time. The nanoparticles were non-toxic to cells even at high concentration of nanoparticles. Cells maintained normal morphology and cell adhesion capacity when incubated with nanoparticles. The results of this study are very encouraging for the development of pullulan nanoparticles as an intracellular delivery system for drugs and genes. Because of their hepatocyte targeting capabilities, further investigations with pullulan nanoparticles for receptor-mediated endocytosis would be advantageous.
Acknowledgements
The authors would like to thank Professor A.S.G. Curtis and Dr. Stephen J. Yarwood, IBLS, University of Glasgow, Glasgow, U.K. for encouraging us to work in their laboratory. The authors would also like to thank Dr. Fiona White (Department of Neurology, University of Glasgow, Glasgow, U.K.) for reading the manuscript.
References
Moghimi, S.M.; Hunter A.C. and Murray, J.C., Long circulating and target specific nanoparticles: theory to practise. Pharm. Rev., 53:283-318, 2001.
Hashida, M.; Nishikawa, M. and Takakura, Y., Receptor-mediated cell specific delivery of drugs to the liver and kidney, In N. Ogata, S.W. Kim, J. Fiejen and T. Okano (eds.) Advanced biomaterials in biomedical engineering and drug delivery systems, Springer-Verlag, Tokyo, Japan, pp 86-90, 1996.
Chawla, J.S. and Amiji, M.M., Biodegradable poly(varepsilon -caprolactone) nanoparticles for tumor-targeted delivery of tamoxifen, Int J Pharm., 249(1-2):127-138, 2002.
Tomlinson, E., Biological opportunities for site specific drug delivery using particulate carriers. In: P. Johnson, J.G. Lloyd-Jones Eds. Drug delivery systems. Fundamentals and Techniques., Ellis Harwood Ltd. Chichester, UK, 32-65, 1987.
Stolnik, S.; Illum, L. and Davis, S.S., Long circulating microparticulate drug carriers. Adv. Drug. Del. Rev., 16:195–214, 1995.
Hawley, A.E.; Davis, S.S. and Illum, L., Targeting of colloids to lymph nodes: influence of lymphatic physiology and colloidal characteristics. Adv. Drug Del. Rev., 17:129–148, 1995.
Ishida, O.; Maruyama, K.; Sasaki, K. and Iwatsuru, M., Size-dependent extravasation and interstitial localization of polyethyleneglycol liposomes in solid tumor-bearing mice. Int. J. Pharm., 190:49–56, 1999.
Schiffelers, R.M.; Bakker-Woudenberg, I.A.; Snijders, S.V. and Storm, G., Localization of sterically stabilized liposomes in Klebsiella pneumoniae-infected rat lung tissue: influence of liposome characteristics. Biochim. Biophys. Acta, 1421:329–339, 1999.
Bawa, R.; Siegel, R.; Karel, M. and Langer, R., An explanation for the controlled release of macromolecules from polymers. J. Cont. Rel., 1 (1985) 259-267.
Miller, E.; Peppas. N.A., and Winslow, D.N., Morphological changes of ethylene/vinyl acetate based on controlled delivery systems during release of water-soluble solutes. J. Memb. Sci., 14:79-92, 1983.
Li, J.K.; Wang, N. and Wu, X.E., A novel biodegradable system based on gelatin nanoparticles and poly(lactic-co-glycolic acid) microspheres for protein and peptide drug delivery. J. Pharm. Sci., 86(8):891-895, 1997.
Hora, M.S.; Rana, R.K., Tice, T.R., Gilley, R. M. and Hudson, M.E., Release of human serum albumin from poly(lactic-co-glycolic acid) microspheres. Pharm. Res., 7(11):1190-1194, 1990.
Jeffery, H.; Davis, S.S. and O’Hagan, D.T., The preparation and characterization of poly(lactic-co-glycolic acid) microparticles.II the entrapment of a model protein using a water-in-oil-in-water emulsion solvent technique. Pharm. Res., 10(3):362-368, 1993.
Ruiz, J.M. and Benoit, J.P., In vivo peptide release from poly(lactic-co-glycolic acid) copolymer 50/50 microspheres. J. Cont. Rel., 16:177-186, 1991.
Heya, T.; Okada, H.; Ogawa, Y. and Toguchi, H., Factors influencing the profiles of TRH release from poly(lactic-co-glycolic acid) microspheres. Int. J. Pharm., 72:199-205, 1991.
Salzman, E.W., Polyethleneglycol oxide as a biomaterial. Am. J. Soc. Artif. Intern. Organs, 6:60-72, 1983.
Ward, A.G. and Courts, A., The Science and technology of Gelatin. Academic Press, New York, 1977.
Akiyoshi, K. and Sunmoto, J., Supramolecular assembly of hydrophobized polysacchrides. Supramol. Sci. 3:157-163, 1996.
Na, K. and Bae, Y.H., Self-assembled hydrogel nanoparticles responsive to tumor extracellular pH from pullulan derivative/sulphonamide conjugate: characterization, aggregation and adriamycin release in vitro. Pharm. Res., 19(5):681-688, 2002.
Jeong, Y.; Nah, J-W.; Na, K.; Cho, C.S. and Kim, S.H., Self assembling nanospheres of hydrophobized pullulans in water, Drug Dev. Ind. Pharm, 25(8):917-927, 1999.
Na, K.; Seong-Lee, E.; Bae Y.H., Adriamycin loaded pullulan acetate/sulfonamide conjugate nanoparticles responding to tumor pH: pH-dependent cell interaction, internalization and cytotoxicity in vitro. J Cont. Rel.., 87(1-3):3-13, 2003.
Akiyoshi, K.; Sasaki, Y. and Sunmoto, J., Molecular chaperone like activity of hydrogel nanoparticles of hydrophobized pullulan: thermal stabilization with refolding of carbonic anhydrase B. Bioconjugate Chem., 10(3):321-324, 1999.
Bagwe, R.P., Kanicky, J.R., Palla, B.J., Patanjali, P.K. and Shah, D.O., Improved drug delivery using microemulsions: rationale, recent progress, and new horizons. Crit. Rev. Ther. Drug Carrier Syst.,18(1):77-140, 2001
Leong, Y.S. and Candau, F., Inverse microemulsion polymerization. J. Phys. Chem., 86:2269, 1982.
Mosmann, T., Rapid colorimetric assay for cellular growth and survival: application to proliferation and cytotoxic assay. J. Immunol. Methods, 95:55-63, 1993.
Hou, M.J.; Kim, M. and Shah, D.O. A light scattering study on the droplet size and interdroplet interaction in microemulsion of AOT-oil water systems. J. Colloid Interf. Sci., 123:398-412, 1988.
Munshi, N.; De, T.K. and Maitra, A.N. Size modulation of polymeric nanoparticles under controlled dynamics of microemulsion droplets. J. Colloid Interf. Sci. 190(2):387-391, 1997.
Absolom, D.R.; Zingg, W. and Neumann, A.W., Protein adsorption to polymer particles: role of surface properties. J. Biomed. Mater. Res. 21:161-171, 1987.
Haas, T.A. and Plow, E.F. Integrin-ligand interactions: a year in review. Curr Opin. Cell Biol. 6:656-662, 1994.
Hallab, N.J.; Bundy, K.J.; O'Connor, K.; Clark, R. and Moses, R.L., Cell adhesion to Biomaterials: Correlations between surface charge, surface roughness, adsorbed protein and cell morphology. J. Long term Effects Med. Implants, 5(3):209-231, 1995.
Yuen, S., Pullulan and its applications, Process Biochem. 9 (9):7-9, 1974.
Jeanes, A., Dextrans and pullulans: industrially significant, ACS Symp. Ser. 45:284–298, 1977.
Gibbs, P.A., Seviour, R.J., Pullulan, in: S. Dumitriu (Ed.), Polysaccharides in Medical Applications, Marcel Dekker, New York, U.S.A. 1996, 59–86.
Kaneo, Y.; Tanaka, T.; Nakano, T. and Yamaguchi, Y., Evidence for receptor-mediated hepatic uptake of pullulan in rats. J. Cont. Rel. 70 (3): 365-373, 2001.
Xi, K.; Tabata, Y.; Uno, K.; Yoshimoto, M.; Kishida, T.; Sokawa, Y. and Ikada, Y., Liver Targeting of Interferon Through Pullulan Conjugation., Pharm. Res. 13 (12):1846-1850, 1996.
Corresponding Author: Mona Gupta, Division of Biochemistry and Molecular Biology, Institute of Biomedical and Life Sciences, Davidson Building, University of Glasgow, Glasgow G12 8QQ, Scotland, United Kingdom. m.gupta@bio.gla.ac.uk
Published by the Canadian Society for Pharmaceutical Sciences.
Copyright © 1998 by the Canadian Society for Pharmaceutical Sciences.
http://www.ualberta.ca/~csps